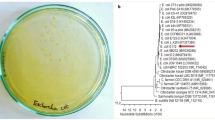

Abstract
The harmful influences of global warming on rabbit reproduction and industry attract global attention. Zinc (Zn) is an important trace element with a wide list of functions in the male reproductive system. The aim of this study was to estimate the effects of different forms of zinc supplementation, as organic (Zn methionine), nano (nano Zn oxide) as indirect way to minimized it impact on environment, and inorganic (Zn sulphate) on physiological parameters, semen quality, anti-oxidative status, hormonal profiles of male rabbits subjected to server heat stress. Thirty-six V-line bucks (6–7 months old, 2842.29 ± 34.46 g weight) were randomly distributed to 4 groups, bucks in 1st group (control group, Con) fed basal diet without Zn supplementation, the 2nd, 3rd and 4th groups fed basial diet with 30 mg/kg of zinc methionine (Zn-Met), nano zinc oxide (ZnO-NPs), and zinc sulphate (Zn-S), respectively for a period of 10 weeks suffered from severe heat stress of environmental ambient temperature (over 32 of temperature humidity index, THI). Semen samples were collected and evaluated for volume, pH, motility, concentration, viability, initial fructose, and seminal plasma antioxidant concentration. Liver, kidney function, hormonal and antioxidant profile were measured in blood serum. The results revealed that, compared to control, all forms of Zn supplementation used significantly improved kidney function (creatinine), serum antioxidant (SOD and CAT), physiological parameters, especially on 1st month of the experiment, and seminal plasma antioxidant (SOD and CAT) of heat stressed bucks. Likewise, semen quality in terms of sperm concentration, sperm viability, and initial fructose enhanced significantly (P ≤ 0.05) by ZnO-NPs supplementation. Zinc methionine supplementation significantly improved liver function and decreased seminal plasma TBARs. Treatments with Zn-Met and ZnO-NPs increased seminal TAC and blood testosterone levels with reduced blood cortisol levels compared to other groups. Severe heat stress could be counteract by inclusion Zn with studied forms Zn-Met and ZnO-NPs at recommended dose (30 mg/kg diet) to improve semen quality and antioxidant status.
Similar content being viewed by others
Introduction
Recently, global warming and heat stress represent the main challenges that contribute to the significant reduction in rabbit semen quality, leading to a significant decrease in sexual behavior, hormonal imbalances, an increase in abnormal sperm; a drop in sperm production, and finally a decrease in fertilization capacity and fertility1, especially with the highly sensitively to heat stress due to lack of sweat glands, except the ear1. Moreover, many blood biochemicals dis-balances in male rabbit were occurred by exposure to thermal stress2. Sperm are rich in polyunsaturated fatty acids with low levels within the cytoplasm3. Heat stress caused a higher level of inflammatory responses in the blood, resulting in a decrease in immunological function and a potential for apoptosis spermatozoa4. In addition, thermal stress caused an increase in oxidative stress, which in turn increased tissue damage by accelerating lipid peroxidation2 and significantly weakening antioxidant defense5, with lipid peroxidation followed in cellular damage6.
Several methods have been used to prevent the negative impacts of heat stress in buck rabbits, including phytogenic, minerals, and vitamins7. Many microelements are successfully used to reduce the damaging effects or avoid harmful impacts of heat stress1. Zinc is one of many series components that control the oxidative stress of cells8. In addition, zinc is the second richest trace element after iron, which plays an important role in the male reproductive process because of their high activity at the molecular level9,10, and involved in various enzyme activities and hormone functions11. Zinc is an effective antioxidant owing key role to catalytic, coactive, or structural roles in different cofactor including more than 300 enzymes12 such as SOD; more than 2000 transcription factors13, involved in the biosynthesis of DNA and cell division14, gene expression15, and immune protection16. Overall, zinc acts as an antioxidant stress agent by inhibition of oxidation of macromolecules such as DNA and proteins, as well as the inhibition of inflammatory response, subsequently downregulation of ROS production17. Inorganic zinc bioavailability in animals is low and large amounts of zinc are excreted into faeces, resulting in environmental pollution and waste of zinc resources. Nano-zinc can be used at lower doses and indirectly prevents environmental contamination18. The nano-zinc (particle size is below 100 nm) is more effective, available, and absorbed easier19, while it bypasses through the stomach wall and into body cells more quickly than ordinary minerals with larger particle size20.
Therefore, the objective of the present study was to determine whether the use of various zinc sources, such as zinc methionine, nano zinc oxide and zinc sulphate, under heat stress conditions could improve the semen of the quality of the rabbit bucks, their hormonal status, and their antioxidant status.
Material and method
Location and ethics statement
The study was carried out at the Department of Animal and Fish Production, Faculty of Agriculture (Saba- Basha), Alexandria University, Alexandria, Egypt (31° 12′ 20.7108′′ N, 29° 55′ 28.2936′′ E). All experimental procedures and handling of buck rabbits were approved by the Alexandria University Institutional Animal Care and Use Committee (Approval Number: 03/19/03/18/1/15), during the summer season (July to September 2021). The experiment was carried out according to relevant guidelines and regulations. Our animal research reports follow the recommendations of the ARRIVE Guidelines.
Zinc source, animal, and diets
Thirty-six fertile V-line male rabbits, 6–7 months old with body weight (2842.29 ± 34.46 g), were used. Live body weights of rabbit bucks were recorded at the beginning of the experiment and at the end. Body weight change was calculated. The bucks were individually caged in wire batteries with a normal daylight (16–17 h). All rabbits were adapted in the experimental rabbit shed for 2 weeks. The rabbits were randomly distributed into four groups (n = 9 bucks per group) as follows: the first group (control group) fed a base diet without Zn supplementation, the second, third and fourth groups fed a base diet with 30 mg/kg of zinc methionine (Zn-Met, Mintrix® Zn was purchased from United BioMed for feed additives, Cairo, Egypt), nano zinc oxide (ZnO-NP, size of < 100 nm; surface area m2 g−1, purity > 97 obtained by Sigma-Aldrich, Saint Louis, USA) and zinc sulphate (ZnS provided by El- Gomhoria Co. for Chemicals and Pharmaceuticals, Alexandria, Egypt), respectively according to recommendation doses of21,22 for ZnO NPs and close to recommendation doses of23 for Zn-Met and ZnS. The experiment was carried out according to relevant guidelines and regulations. The experiment lasted 10 weeks. Feed and fresh clean water were provided ad libitum. The basic diet was formulated as (16% yellow corn grain, 7% barley, 19% wheat bran, 20% soybean, 24% clover hay, 10% wheat straw, 2% beet molasses, 0.3% premix, 0.2% calcium carbonate, 0.8% dicalcium phosphate, 0.5% salt, 0.15% l-lysine, 0.05% methionine DL) and the calculated chemical composition was (88.71% dry matter, 17.21% crude protein, 14.81% crude fiber, 2.47% fat, 8.25% ash) according to the recommendation of24.
Microenvironment data
Throughout the experimental period (10 weeks), ambient temperature (°C) and relative humidity (%) were recorded daily at midday using a Mercury-room thermometer and hygrometer, respectively. the weekly temperature-humidity index (THI) was determined by the equation defined by25. The mean values of THI were classified according to26.
Physiological parameters
The rectal temperature (RT) and the respiration rate (RR) were recorded twice (4th and 8th weeks of the experiment) at 12:00–2:00 PM. A clinical digital thermometer and stopwatch were used to measure RT by inserting the thermometer 2 cm into the rectum for 2 min, inclined toward the wall of the rectum. Visual counting of nasal movement per 1 min without disturbing the rabbits by using a hand counter to determine the RR.
Semen collection and evaluation
The semen samples of each rabbit buck were collected weekly in the morning (8 am) for 10 weeks using an artificial vagina by exposing a mature female rabbit to the bucks as a teaser during collecting. After collection, the ejaculate volume without gel was recorded in graduated collecting tubes to the nearest 0.01 ml (excluding the gel plug). Semen pH was directly measured by using pH paper strips (range: 0–14, resolution: 1.0 pH unit; Sigma-AldrichVR). Sperm mass activity was determined manually according to27, giving an arbitrary score of 0 to 3. The individual progressive motility was examined by diluted semen with normal saline (1:100) and transferred to a warm glass slide (37 °C) covered with a cover slip and examined under a light microscope (400× magnification) on a scale of 0 to 100% according to28. Sperm concentration (*106/mm3) was evaluated in duplicate using a Neubauer hemocytometer after dilution with distilled water (1:200). Sperm viability was determined using semen smears mixed with Eosin-Nigrosin stain and viable and non-viable spermatozoa were determined by counting 200 sperm under a light microscope29. The initial fructose concentration of the collected semen was determined by a spectrophotometer using commercial kits (Biodiagnostic, Egypt) according to the manufacturer's instructions. At the 10th week of the experiment, the seminal plasma of 4 bucks of each treatment was separated from the mass of the sperm cells by centrifugation at 700g for 15 min. The supernatant (seminal plasma) was collected and kept at − 20 °C until analysis. Seminal plasma SOD, CAT, TBARs, and TAC were verified by colorimetric techniques using commercial kits (purchased from Bio-diagnostic, Giza, Egypt), according to the manufacturers’ instructions.
Blood biochemical
At the end of 10th week of the experiment period, blood samples were collected morning before adding feed, from the margin ear of bucks after disinfecting with a sanitizer solution in sterilized tube. Then the blood samples were centrifuged at 700g for 10 min to obtain serum. The serum obtained was transferred to sterile Eppendorf® tubes and stored at − 20 °C. Serum samples were analyzed for AST and ALT according to30, urea31, creatinine32,33, SOD34, CAT35,36, TBARS37, and TAC38. These analyses were performed using commercial kits (acquired from Bio-diagnostic, Giza, Egypt).
The cortisol (MBS2005085) and testosterone (MBS704954) enzyme-linked immunosorbent assay (ELISA) MyBioSource kits (sunny Southern California, San Diego, USA) were employed in quantifying the concentrations of cortisol and testosterone, respectively, following the manufacturer’s protocols.
Statistical analyses
The experimental data were subjected to a one-way analysis of variance analyzed (ANOVA) via the GLM procedure using Statistical Analysis Software (IBM SPSS Statistics for Windows, Version 20, Chicago, IL, USA). Each buck rabbit is an experimental unit that provides an independent measurement. All percentage data were arc-sine transformed prior to the approximate normal distribution. The Tukey test was used to compare the differences between the means when significant F values were observed at the levels of p < 0.05, according to the following statistical model: One-way model: YiK = μ + Xi + eik where: YiK = the response variable; μ = the overall mean; Xi = the fixed effect of treatment (control, 30 mg Zn MET, 30 mg Naon ZnO, and 30 mg ZnSo4); eik = the residual error. Figures were fitted by the SigmaPlot (software 14.0 Systal software Inc).
Ethics approval and consent to participate
All experimental procedures and handling of buck rabbits were approved by the Alexandria University Institutional Animal Care and Use Committee.
Results
Microclimate and physiological parameters
Figure 1 shows the weekly ambient temperature, humidity, and THI during the experiment period. The weekly temperature humidity index under the experimental conditions ranged from 31.58 to 38.49. The recorded THI values clearly showed that the bucks suffered severe heat stress. Physiological parameters (RR and RT) during 1st and 2nd months of the experimental period are presented in Fig. 2. The result revealed that all sources of Zn supplementation in this study significantly succeeded in decreasing both RR and RT values of heat stressed bucks on the first month and RR only on the second month. From Fig. 2 it can be shown that the inclusion of zinc in heat-stressed buck rations still has an effect on RT but the effect is not significant.
Body weight and semen quality
The data in Table 1 indicated that the initial and final body weight of heat stressed bucks did not differ in all experimental groups. While the change of body weight due to zinc treatments was significant compared to the control group Table 2 shows that the most semen parameters were significantly improved by zinc supplementation except semen pH, mass motility and individual motility.. The highest semen volume was collected from the ZnS group. While both ZnO NPs and ZnS significantly recorded the highest sperm concentration compared to other treatments. All zinc treatments significantly enhanced the percentage of viability of the sperm. The seminal plasma initial fructose level (P < 0.05) was increased by inclusion zinc with different forms in heat stressed bucks’ rations compared to the control group and this effect was significant with zinc Met and ZnO NPs only.
The antioxidant status of seminal plasma of heat stressed bucks such of SOD and CAT levels (Fig. 3) were significantly improved by zinc treatment with different sources. As well, the TBAR concentration in seminal plasma showed a decrease in all zinc supplementation groups compared to the control group and this decrease was significant with Zn Met.
Biochemical and hormonal analysis
As described in Table 3, liver functions (serum concentrations of AST and ALT) were decreased significantly with Zn-Met supplementation compared to the control group, while the other Zn treatments did not differ than the control group. All zinc treatments improved kidney function as reflected in decreasing creatinine level. From Table 3, blood antioxidant status, whereas, SOD, CAT and TAC were improved and TBARS was decreased by adding Zn from different sources to heat stressed bucks rations and this effect was significant with SOD and TAC. Furthermore, the results of our study in Fig. 4 showed that all zinc treatments decreased serum cortisol levels with elevated serum testosterone concentrations of heat stressed bucks.
Discussion
Temperature humidity index (THI) is used to evaluate the degree of heat stress by the combined both ambient temperature and relative humidity estimate the severity of heat stress. This index is widely used in hot and humid areas around the world to assess the impact of heat stress39. The weekly THI values clearly indicated that the buck rabbits suffered severe thermal stress. Zinc is an effective antioxidant and plays a vital physiological role for animal health, synthesis of more than 300 enzymes involved in metabolism process40, synthesis proteins, immune system activation, bone development41, DNA synthesis, cell division, gene expression, and biological functions42. In addition to reducing the negative impact of both cold and heat stressors43. Zinc methionine is organic forms of Zn are generally bound to methionine amino-acid complex, it may be better absorption and more available to animal by interaction with other elements, especially Cu, Fe, and Ca44. Nano-zinc oxide is smaller than 100 nm causes increasing absorption rate and availability40, and is more biologically effective45 by bypassing conventional physiological ways of nutrient distribution, and transport across tissue and cell membranes, as well as protecting compounds against destruction before reaching their targets19, and reaching target cells more quickly than ordinary minerals with larger particle size20. At the same time, using nano-Zn oxide is useful to avoid excessive supplementation with Zn in animal diets and lowest the accumulation of Zn in soils after intensive animal farming46, thus reducing the potential risks for environmental pollution18,47.
Physiological parameters such as respiration rate and rectum temperature are considered direct indexes of climatic stress48 and accordingly measure the degree of discomfort/comfort or adaptability of bucks. Our result revealed that all sources Zn supplementation significantly decrease RR and RT values of heat stressed bucks on 1st month and RR only on 2nd month. The positive impact of zinc on physiological parameter of heat stressed buck may be due to that zinc reduced stress on the rabbits by enhancing the bioavailability of other minerals49. The insignificant RT values in the 2nd month of all zinc treatments may be due to the development of metabolic mechanisms of all experimental bucks to adapt to heat stress to a tolerable level.
The initial and final body weights of the heat-stressed bucks did not differ in all experimental groups. Although the body weight change of all zinc treatments was significantly greater compared to the control bucks, that cleared that all zinc treatments alleviated the negative effect of heat stress.
Zinc sulphate treatment significantly improved semen volume, sperm concentration and sperm viability; a similar improvement was obtained by50,51 who concluded a significant increase in semen volume, total live sperm concentration and sperm mobility due to zinc sulphate dietary supplementation in heat-stressed rabbit males. Increased semen volume of Zn-s treatment may contribute to increased prostatic fluid9. Furthermore, nanozinc significantly increased each of sperm concentration, sperm viability, and initial fructose compared to the control group could be due to improvement in buck antioxidant status52. Similar results were found by45 who reported that nanoparticles have biological effects that improve male fertility by enhancing sperm quality. Also,53 observed that supplemented young rams’ diet with 50 mg/kg or 100 mg/kg nano zinc practical improved epididymal semen quality. Increasing the percentage of sperm viability of nanozinc bucks may be due to improvement the functionality of sperm plasma membranes without any significant effect on motility parameters54. Furthermore, the improvement in sperm concentration of bucks fed a diet supplemented with nano-zinc could be due to increased antioxidant enzymes activity of testicular tissue55 or seminal plasma in the current study that protects sperm against oxidative stress. In addition, Zn-Met significantly enhanced the viability sperm percentage and initial fructose in the present findings.
Additionally, the membrane of rabbit sperm cells is rich in polyunsaturated fatty acids that make sperm susceptible to lipid peroxidation56. Other semen characteristics such as pH and motility (mass and individual) were not differ among experimental groups. Our results agree with those of57 and58 who reported that supplemental organic and non-organic zinc improved quantitative and qualitative characteristics of semen reproductive efficiency59 and fertility by lower blood kidney parameters that decrease ROS production and increased progressive motility, acrosome reaction and capacitation60. Viable sperm percentage did not effect by all zinc treatments in the current results, this observation has a harmoniousness with previous studies of9,61. In general, zinc affects reproductive characteristics by stimulating and protecting the germinal epithelium of seminiferous tubules and promoting the production and secretion of testosterone62, as shown in the present findings, and therefore influences spermatogenesis63. Besides, the positive result of all zinc treatments on sperm concentration and spermatogenesis may be due to the production of sperm necessitates extensive cell division by influencing mitotic and meiotic cell divisions, synthesis of DNA and RNA by improving the activity of DNA and RNA polymerase (Zn-containing enzymes)64. Increasing initial fructose in all zinc treated bucks as compared to the control bucks may be attributed to the effect of treatments on fructogenesis in seminal vesicles of heat stressed rabbits.
Antioxidant status such as SOD and CAT levels of the seminal plasma of heat-stressed bucks in the present findings were significantly improved by different sources of zinc treatments. Although zinc methionine supplementation was more effective in reducing the seminal plasma TBAR concentration compared to other groups. These results agreed with those presented by65 who reported that Zn supplementation had a beneficial effect on the anti-oxidative status of seminal plasma, which may provide better protection to spermatozoa from oxidative damage, and also improve the concentration of testosterone as is shown in the current study which may play a role in the production of good quality semen.
Liver functions were significantly improved as AST and ALT concentrations were reduced in Zn-Met group compared to the control group with no significant effect of other zinc treatments. The positive effect of Zn treatments on semen quality may be due to the revealed negative relationship between liver enzymes such as ALT and GGT and sperm concentration, total testosterone and LH due to the formation of pro-oxidant species formation66. Our results were in agreement with67,68 who found that supplementation with ZnO-NP in rabbit diets significantly reduced serum levels of AST and ALT activities compared to the control group. All zinc treatments improved kidney function as reflected in the decrease in creatinine values. The current results were agreed with69,70 that found the diets supplemented with 50 and 100 mg/kg of Zn-Met significantly decreased blood creatinine concentration compared to the control group. On the other hand, the result disagreed with71 who reported that plasma creatinine concentration did not change in rabbit fed diet supplemented with Zn.
Heat stress decreases antioxidant status, which is one of the most important physiological changes in response to high ambient temperature in animals that increases oxidative stress and immune suppression72. Dietary supplementation of different Zn sources in the current study improved the serum antioxidant status (SOD and TAC levels) with no significant effect between ZnO NPs and control groups. The improvement in blood antioxidant status may be due to zinc being considered an effective antioxidant by having catalytic, coactive, or structural functions in different enzymes such as SOD, which controls many physiological processes such as metabolism and immune function73, or by inhibiting the oxidation of macromolecules such as DNA and proteins17 or by maintaining the activities of radical scavenging enzymes40. The improvement in blood antioxidant status may be associated to the enhancing in seminal antioxidant status as mentioned earlier in our study, which illustrated that zinc prevents the oxidative damage to the sperm cells and thereby improve the fertility11. From Fig. 3 TBARs seminal plasma was affected by Zn supplementation, whereas, TBARs was decreased in Zn treatments compared to the control group but this effect was nonsignificant. Our results disagree with the findings of74 who showed that plasma TBARs and plasma lipid peroxides concentration was reduced significantly by zinc supplementation in rabbit diets.
Animals that exposed to ecological stressors such as extremes of temperatures, neurons in the CNS are stimulated, that activated of the hypothalamic pituitary adrenal axis leading to stimulate the cortex of the adrenal gland to produce and release corticosteroids (cortisol)75. However, zinc had an effect on the severe heat stress by decreasing cortisol levels which observed in the current study, whereas all zinc treatments declined serum cortisol levels. Testosterone as a sex hormone has a positive impact on semen quality and reproductive physiology76. In the present findings, all zinc forms led to elevated serum testosterone concentration of heat stressed bucks, which reflected the improvement in semen characteristics which was in consistency with previous studies. Many studies supported our results on improving blood testosterone concentration61, which helps in building protein, and is necessary for sexual desire and erections77.
Conclusions
Current data revealed a significant positive improvement in body weight change, blood kidney function (creatinine), serum antioxidant (SOD and CAT), physiological parameters, especially in the 1st month of experiment, and seminal plasma antioxidant (SOD and CAT) of heat stressed bucks with the three forms of dietary Zn supplementation. Furthermore, semen quality in terms of sperm concentration, viability, and initial fructose improved significantly with ZnO-NPs supplementation. Zinc methionine supplementation significantly improved liver function and reduced seminal plasma TBARs. Both ZnO-NPs and Zn-Met improved seminal TAC and blood testosterone with reduced blood cortisol levels. Therefore, it concluded that the recommended forms of Zn in the dose of 30 mg/kg diet are zinc methionine and ZnO-NPs, rather than ZnS during the severe heat stress conditions to improve semen quality, and serum and seminal antioxidant status of buck rabbits.
Data availability
The data used to support our study’s findings are included in the article, and data coding is available from the corresponding author upon reasonable request.
Abbreviations
- ANOVA:
-
A one-way analysis of variance analyzed
- CAT:
-
Catalase
- CNS:
-
Central nerves system
- DNA:
-
Deoxyribonucleic acid
- ELISA:
-
Enzyme-linked immunosorbent assay
- AST:
-
Aspartate transaminase
- ALT:
-
Alanine transaminase
- pH:
-
Potential of hydrogen
- RR:
-
Respiration rate
- RT:
-
Rectal temperature
- SOD:
-
Superoxide dismutase
- TBARs:
-
Thiobarbituric acid reactive substances
- THI:
-
Temperature humidity index
- Zn:
-
Zinc
- Zn-Met:
-
Zinc methionine
- ZnO-NPs:
-
Nano zinc oxide
- ZnS:
-
Zinc sulphate
References
Sheiha, A. M. et al. Effects of dietary biological or chemical-synthesized nano-selenium supplementation on growing rabbits exposed to thermal stress. Animals 10, 1–16 (2020).
Hosny, N. S., Hashem, N. M., Morsy, A. S. & Abo-Elezz, Z. R. Effects of organic selenium on the physiological response, blood metabolites, redox status, semen quality, and fertility of rabbit bucks kept under natural heat stress conditions. Front. Vet. Sci. 7, 290 (2020).
El-Gindy, Y. M. Improvement in quality and storage ability of rabbit semen by using black or thyme seed as dietary supplementation. J. Anim. Physiol. Anim. Nutr. (Berl.) https://doi.org/10.1111/jpn.13596 (2021).
Chaidanya, K. et al. Impact of heat stress, nutritional stress and combined (heat and nutritional) stresses on rumen associated fermentation characteristics, histopathology and HSP70 gene expression in goats. J. Anim. Behav. Biometeorol. 5, 36–48 (2020).
Rezaei, N. et al. Effects of l-Carnitine on the follicle- stimulating hormone, luteinizing hormone, testosterone, and testicular tissue oxidative stress levels in streptozotocin-induced diabetic rats. J. Evid.-Based Integr. Med. 23, 1–10 (2018).
Gaschler, M. M. & Stockwell, B. R. Lipid peroxidation in cell death. Biochem. Biophys. Res. Commun. 482, 419–425 (2017).
Farghly, M. F. A., Alagawany, M. & Abd El-Hack, M. E. Feeding time can alleviate negative effects of heat stress on performance, meat quality and health status of turkey. Br. Poult. Sci. 59, 205–210 (2018).
Marklund, S. Distribution of CuZn superoxide dismutase and Mn superoxide dismutase in human tissues and extracellular fluids. Acta Physiol. Scand. Suppl. 492, 19–23 (1980).
Zhao, J. et al. Zinc levels in seminal plasma and their correlation with male infertility: A systematic review and meta-analysis. Sci. Rep. 6, 1–10 (2016).
Oliveira, C. E. A., Badu, C. A., Ferreira, W. M., Kamwa, E. B. & Lana, A. M. Q. Effects of dietary zinc supplementation on spermatic characteristics of rabbit breeders. in 8th World Rabbit Congress, Mexico 7–10 (2004).
Hemalatha, K. et al. Effect of dietary supplementation of organic zinc and copper on in vitro semen fertility in goat. Small Rumin. Res. 161, 68–72 (2018).
Abd El-Hack, M. E. et al. Effect of dietary supplementation of organic zinc on laying performance, egg quality and some biochemical parameters of laying hens. J. Anim. Physiol. Anim. Nutr. (Berl.) 102, e542–e549 (2018).
Xu, X. et al. Effects of chromium methionine supplementation with different sources of zinc on growth performance, carcass traits, meat quality, serum metabolites, endocrine parameters, and the antioxidant status in growing-finishing pigs. Biol. Trace Elem. Res. 179, 70–78 (2017).
Mateos, G. G., Rebollar, P. G. & de Blas, C. Minerals, vitamins and additives, in Nutrition of the Rabbit 119–150 (CABI Wallingford UK, 2010).
Macpherson, L. J. et al. The pungency of garlic: Activation of TRPA1 and TRPV1 in response to allicin. Curr. Biol. 15, 929–934 (2005).
Yan, J. Y., Zhang, G. W., Zhang, C., Tang, L. & Kuang, S. Y. Effect of dietary organic zinc sources on growth performance, incidence of diarrhoea, serum and tissue zinc concentrations, and intestinal morphology in growing rabbits. World Rabbit Sci. 25, 43–49 (2017).
Prasad, A. S. & Bao, B. Molecular mechanisms of zinc as a pro-antioxidant mediator: clinical therapeutic implications. Antioxidants 8, 164 (2019).
Swain, P. S., Rao, S. B. N., Rajendran, D., Dominic, G. & Selvaraju, S. Nano zinc, an alternative to conventional zinc as animal feed supplement: A review. Anim. Nutr. 2, 134–141 (2016).
Hett, A. Nanotechnology: Small Matter, Many Unknowns (Swiss Reinsurance Company, 2004).
Bunglavan, S. J., Garg, A. K., Dass, R. S. & Shrivastava, S. Use of nanoparticles as feed additives to improve digestion and absorption in livestock. Livest. Res. Int 2, 36–47 (2014).
Hassan, F. A. M., Mahmoud, R. & El-Araby, I. E. Growth performance, serum biochemical, economic evaluation and IL6 gene expression in growing rabbits fed diets supplemented with zinc nanoparticles. Zagazig Vet. J. 45, 238–249 (2017).
Qureshi, A. A., Abuirmeileh, N., Din, Z. Z., Elson, C. E. & Burger, W. C. Inhibition of cholesterol and fatty acid biosynthesis in liver enzymes and chicken hepatocytes by polar fractions of garlic. Lipids 18, 343–348 (1983).
Luis-Chincoya, H., Herrera-Haro, J. G., Pro-Martínez, A., Santacruz-Varela, A. & Jerez-Salas, M. P. Effect of source and concentration of zinc on growth performance, meat quality and mineral retention in New Zealand rabbits. World Rabbit Sci. 29, 151–159 (2021).
National Research Council. Nutrient requirements of rabbits. (1977).
Marai, I. F. M., Habeeb, A. A. M. & Gad, A. E. Rabbits’ productive, reproductive and physiological performance traits as affected by heat stress: A review. Livest. Prod. Sci. 78, 71–90 (2002).
LPHSI, A. Livestock and Poultry Heat Stress Agriculture engineering technology guide. (Clemson University, Clemson, SC. USA, 1990).
Moule, G. B. Field Investigations with Sheep. A Manual of Techniques (C.S.I.R.O., 1965).
Amann, R. P. & Hammerstedt, R. H. Validation of a system for computerized measurements of spermatozoal velocity and percentage of motile sperm. Biol. Reprod. 23, 647–656 (1980).
Shaffer, H. E. & Almquist, J. Vital staining of bovine spermatozoa with an Eosin-Aniline blue staining mixture (abstract). J. Dairy Sci. 31, 677–678 (1948).
Reitman, S. & Frankel, S. A colorimetric method for the determination of serum glutamic oxalacetic and glutamic pyruvic transaminases. Am. J. Clin. Pathol. 28, 56–63 (1957).
Fawcett, J. & Scott, J. A rapid and precise method for the determination of urea. J. Clin. Pathol. 13, 156–159 (1960).
Bartels, H., Böhmer, M. & Heierli, C. Serum creatinine determination without protein precipitation. Clin. Chim. Acta. 37, 193–197 (1972).
Larsen, K. Creatinine assay by a reaction-kinetic principle. Clin. Chim. Acta. 41, 209–217 (1972).
Nishikimi, M., AppajiRao, N. & Yagi, K. The occurrence of superoxide anion in the reaction of reduced phenazine methosulfate and molecular oxygen. Biochem. Biophys. Res. Commun. 46, 849–854 (1972).
Aebi, H. Catalase in vitro. Methods Enzymol. 105, 121–126 (1984).
Fossati, P., Prencipe, L. & Berti, G. Use of 3,5-dichloro-2-hydroxybenzenesulfonic acid/4-aminophenazone chromogenic system in direct enzymic assay of uric acid in serum and urine. Clin. Chem. 26, 227–231 (1980).
Tappel, A. L. & Zalkin, H. Inhibition of lipide peroxidation in mitochondria by vitamin E. Arch. Biochem. Biophys. 80, 333–336 (1959).
Koracevic, D., Koracevic, G., Djordjevic, V., Andrejevic, S. & Cosic, V. Method for the measurement of antioxidant activity in human fluids. J. Clin. Pathol. 54, 356–361 (2001).
Asemota, O. D., Aduba, P., Bello-Onaghise, G. & Orheruata, A. M. Effect of temperature-humidity index (THI) on the performance of rabbits (Oryctolaguscuniculus) in the humid tropics. Arch. Zootec. 66, 257–261 (2017).
Sallam, A. E., Mansour, A. T., Alsaqufi, A. S., Salem, M.E.-S. & El-Feky, M. M. M. Growth performance, anti-oxidative status, innate immunity, and ammonia stress resistance of Siganus rivulatus fed diet supplemented with zinc and zinc nanoparticles. Aquac. Rep. 18, 100410 (2020).
Suttle, N. F. Mineral Nutrition of Livestock (Cabi, 2022).
Cui, H. et al. Effects of different sources and levels of zinc on growth performance, nutrient digestibility, and fur quality of growing-furring male mink (Mustela Vison). Biol. Trace Elem. Res. 182, 257–264 (2018).
Fawaz, M. A., Südekum, K. H., Hassan, H. A. & Abdel-Wareth, A. A. A. Effects of nanoparticles of zinc oxide on productive performance of laying hens–a review. SVU-Int. J. Agric. Sci. 1, 13–20 (2019).
Bortoluzzi, C. et al. Zinc source modulates intestinal inflammation and intestinal integrity of broiler chickens challenged with coccidia and Clostridium perfringens. Poult. Sci. 98(5), 2211–2219. https://doi.org/10.3382/ps/pey587 (2019).
Falchi, L., Khalil, W. A., Hassan, M. & Marei, W. F. A. Perspectives of nanotechnology in male fertility and sperm function. Int. J. Vet. Sci. Med. 6, 265–269 (2018).
Romeo, A., Vacchina, V., Legros, S. & Doelsch, E. Zinc fate in animal husbandry systems. Metallomics 6, 1999–2009 (2014).
Patil, S. S., Kore, K. B. & Kumar, P. Nanotechnology and its applications in veterinary and animal science. Vet. World 2, 475–477 (2009).
Ganaie, A. H. et al. Biochemical and physiological changes during thermal stress in bovines: A review. Iran. J. Appl. Anim. Sci. 3, 423–430 (2013).
Rajendran, D., Thulasi, A., Jash, S., Selvaraju, S. & Rao, S. B. N. Synthesis and application of nano minerals in livestock industry. In Animal nutrition and reproductive physiology (recent concepts). Satish Ser. Publ. House, Delhi 517–530 (2013).
Moce, E., Arouca, M., Lavara, R. & Pascual, J. J. Effect of dietary zinc and vitamin supplementation on semen characteristics of high growth rate males during summer season. in Proceedings of the 7th World Rabbit Congress 203–209 (2000).
El-Masry, K. A., Nasr, A. S. & Kamal, T. H. Influences of season and dietary supplementation with selenium and vitamin E or zinc on some blood constituents and semen quality of New Zealand White rabbit males. World Rabbit Sci. 2(3), 79–86 (1994).
Raeeszadeh, M., Shokrollahi, B. & Akbari, A. Superior effect of broccoli methanolic extract on control of oxidative damage of sperm cryopreservation and reproductive performance in rats: A comparison with vitamin C and E antioxidant. Theriogenology 181, 50–58 (2022).
Zhang, C. et al. Effect of different Nano-zinc levels in dietary on semen quality, activities of antioxidant enzyme and expression of copper zinc superoxide in epididymis of ram lambs. Sci. Agric. Sin. 48, 154–164 (2015).
Jahanbin, R. et al. Effect of zinc nano-complex on bull semen quality after freeze-thawing process. Anim. Prod. 17, 371–380 (2015).
Afifi, M., Almaghrabi, O. A. & Kadasa, N. M. Ameliorative effect of zinc oxide nanoparticles on antioxidants and sperm characteristics in streptozotocin-induced diabetic rat testes. Biomed. Res. Int. 2015, 153573. https://doi.org/10.1155/2015/153573 (2015).
El-Gindy, Y. M. Improvement in quality and storage ability of rabbit semen by using black or thyme seed as dietary supplementation. J. Anim. Physiol. Anim. Nutr. (Berl) 106, 642–654 (2022).
Geary, T. W. et al. Effect of supplemental trace mineral level and form on peripubertal bulls. Anim. Reprod. Sci. 168, 1–9 (2016).
Kumar, N., Verma, R. P., Singh, L. P., Varshney, V. P. & Dass, R. S. Effect of different levels and sources of zinc supplementation on quantitative and qualitative semen attributes and serum testosterone level in crossbred cattle (Bos indicus $\bf\times $ Bos taurus) bulls. Reprod. Nutr. Dev. 46, 663–675 (2006).
Salim, H. M., Jo, C. & Lee, B. D. Zinc in broiler feeding and nutrition. Avian Biol. Res. 1, 5–18 (2008).
Kowsar, R., Ronasi, S., Sadeghi, N., Sadeghi, K. & Miyamoto, A. Epidermal growth factor alleviates the negative impact of urea on frozen-thawed bovine sperm, but the subsequent developmental competence is compromised. Sci. Rep. 11, 4687 (2021).
Abaspour Aporvari, M. H., Mamoei, M., Tabatabaei Vakili, S., Zareei, M. & Dadashpour Davachi, N. The effect of oral administration of zinc oxide nanoparticles on quantitative and qualitative properties of arabic ram sperm and some antioxidant parameters of seminal plasma in the non-breeding season. Arch. Razi Inst. 73, 121–129 (2018).
Wong, W. Y. et al. Effects of folic acid and zinc sulfate on male factor subfertility: A double-blind, randomized, placebo-controlled trial. Fertil. Steril. 77, 491–498 (2002).
Ghorbani, A., Moeini, M. M., Souri, M. & Hajarian, H. Influences of dietary selenium, zinc and their combination on semen characteristics and testosterone concentration in mature rams during breeding season. J. Appl. Anim. Res. 46, 813–819 (2018).
Dhama, K. et al. Growth promoters and novel feed additives improving poultry production and health, bioactive principles and beneficial applications: The trends and advances-a review. Int. J. Pharmacol. 10, 129–159 (2014).
Kumar, P., Yadav, B. & Yadav, S. Effect of zinc and selenium supplementation on antioxidative status of seminal plasma and testosterone, T4 and T3 level in goat blood serum. J. Appl. Anim. Res. 41, 382–386 (2013).
Ehala-Aleksejev, K. & Punab, M. Serum hepatic enzyme activity in relation to semen quality and serum reproductive hormone levels among Estonian fertile Men. Andrology 4, 152–159 (2016).
Al-Sagheer, A. A., Abdel-Rahman, G., Ayyat, M. S., Gabr, H. A. & Elsisi, G. F. Productive performance response of growing rabbits to dietary protein reduction and supplementation of pyridoxine, protease, and zinc. An. Acad. Bras. Cienc. 92(3), https://doi.org/10.1590/0001-3765202020180989 (2020).
Abdel-Wareth, A. A. A., Amer, S. A., Mobashar, M. & El-Sayed, H. G. M. Use of zinc oxide nanoparticles in the growing rabbit diets to mitigate hot environmental conditions for sustainable production and improved meat quality. BMC Vet. Res. 18, 1–10 (2022).
El-Moghazy, M., El-Fadaly, H. A., Khalifa, E. I. & Mohamed, M. A. Effect of dietary zinc-methionine on growth, carcass traits, antioxidants and immunity of growing rabbits. J. Anim. Poult. Prod. 10, 59–66 (2019).
El-Hamid, A., El-Speiy, M., Hassan, S. & Habbibe, M. Performance, immunity response, blood biochemical and hematological traits of growing male rabbits affected by type water with zinc. Egypt. J. Rabbit Sci. 28, 129–155 (2018).
Raslan, M. A. H., Ismail, Z. S. H. & Abdel-Wareth, A. A. A. Application of zinc oxide nanoparticles on productive performance in rabbit nutrition: A review. SVU-Int. J. Agric. Sci. 2, 278–290 (2020).
El-Gindy, Y. M. et al. Enhancing semen quality, antioxidant status and sex hormones of V-line rabbit bucks fed on supplemented diets with dried moringa leaves. Anim. Biotechnol. 1–10. https://doi.org/10.1080/10495398.2022.2110109 (2022).
Prasad, A. S. Zinc: Role in immunity, oxidative stress and chronic inflammation. Curr. Opin. Clin. Nutr. Metab. Care 12, 646–652 (2009).
Alissa, E. M., Bahijri, S. M., Lamb, D. J. & Ferns, G. A. A. The effects of coadministration of dietary copper and zinc supplements on atherosclerosis, antioxidant enzymes and indices of lipid peroxidation in the cholesterol-fed rabbit. Int. J. Exp. Pathol. 85, 265–275 (2004).
Hau, J., Schapiro, S. J. & Van Hoosier Jr, G. L. Handbook of Laboratory Animal Science: Animal Models Vol. II (CRC Press, 2002).
El-Gindy, Y. M., Zahran, S. M., Hassan, M. A. & Sabir, S. A. Effect on physiological parameters and semen quality upon oral administration of fresh onion juice to V-line rabbit buck during severe heat stress. Anim. Biotechnol. 1–9. https://doi.org/10.1080/10495398.2022.207018 (2022).
Arif, M. et al. Impacts of supplementing broiler diets with a powder mixture of black cumin, Moringa and chicory seeds. S. Afr. J. Anim. Sci. 49, 564–572 (2019).
Acknowledgements
The authors gratefully acknowledge Alexandria University for their support.
Funding
Open access funding provided by The Science, Technology & Innovation Funding Authority (STDF) in cooperation with The Egyptian Knowledge Bank (EKB).
Author information
Authors and Affiliations
Contributions
Y.M.E. designed and conducted the experiments, collected samples, performed sample analyses/statistical analysis, and wrote, reviewed, and the manuscript. S.M.Z. and M.H.A revised the article and provided expert advice to improve the manuscript. A.M.A. performed the animal trial, collected samples, and conducted sample analyses. A.Z.M. helping in data analysis. S.A.M. helped in sampling and data interpretation, including software analysis, validation, and writing, and in reviewing and editing the manuscript. All the authors have read and approved the manuscript.
Corresponding author
Ethics declarations
Competing interests
The authors declare no competing interests.
Additional information
Publisher's note
Springer Nature remains neutral with regard to jurisdictional claims in published maps and institutional affiliations.
Rights and permissions
Open Access This article is licensed under a Creative Commons Attribution 4.0 International License, which permits use, sharing, adaptation, distribution and reproduction in any medium or format, as long as you give appropriate credit to the original author(s) and the source, provide a link to the Creative Commons licence, and indicate if changes were made. The images or other third party material in this article are included in the article's Creative Commons licence, unless indicated otherwise in a credit line to the material. If material is not included in the article's Creative Commons licence and your intended use is not permitted by statutory regulation or exceeds the permitted use, you will need to obtain permission directly from the copyright holder. To view a copy of this licence, visit http://creativecommons.org/licenses/by/4.0/.
About this article
Cite this article
El-Gindy, Y.M., Zahran, S.M., Ahmed, M.H. et al. Counteract severe heat stress by including different forms of zinc in the rabbit bucks’ diet. Sci Rep 13, 12987 (2023). https://doi.org/10.1038/s41598-023-39928-3
Received:
Accepted:
Published:
Version of record:
DOI: https://doi.org/10.1038/s41598-023-39928-3